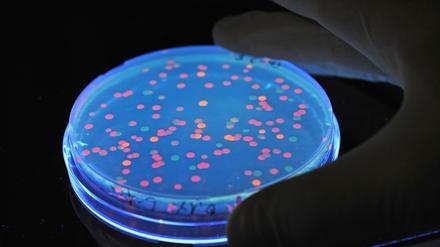
Verschiedene Bevölkerungsgruppen haben ein unterschiedlich hohes Vertrauen in Forscher. (Archivbild)

An einer Leipziger Schule werden sportliche Leistungen nicht mehr bewertet. Alternativen zu Noten zu schaffen, ist längst überfällig. Doch in der Neuerung steckt ein Risiko.

An einer Leipziger Schule werden sportliche Leistungen nicht mehr bewertet. Alternativen zu Noten zu schaffen, ist längst überfällig. Doch in der Neuerung steckt ein Risiko.

Die Potsdamer Firma Daucum setzt sich für mehr Biodiversität ein und berät Städte, Firmen und Privatpersonen. Warum Geschäftsführerin Wanda Born wenig von Insektenhotels hält und wie es besser geht.

Eine Ausweitung der Mütterrente ist das zentrale Thema der sogenannten „Bayern-Agenda“ der CSU. Neben dem gemeinsamen Wahlprogramm der Union will die Partei eigene Schwerpunkte setzen.

Der Berliner Grünen-Politiker Stefan Gelbhaar ist womöglich Opfer einer parteiinternen Intrige geworden. Die Grünen-Spitze äußerte sich lange nicht. Nun reagierte Kanzlerkandidat Robert Habeck.

In der Nacht zu Sonntag gingen wieder Müllcontainer am Schlaatz in Flammen auf. Im Stadtteil ist es in den letzten Wochen immer wieder zu brennenden Mülltonnen und Sperrmüllhaufen gekommen.

Besonders neblig war es am Samstag im Norden Brandenburgs. Für Schwäne scheint das mitunter ein Problem zu sein. Die Polizei rückte gleich mehrfach aus.

Er verbreitete Judenhass, Reichsbürger-Parolen und Verschwörungsglauben. Jetzt versucht Xavier Naidoo ein musikalisches Comeback. Das stößt auf massive Kritik.

Mit gefälschten Rezepten versuchen Unbekannte an teure Arzneimittel zu gelangen. In Berlin fielen Apothekern zweifelhafte Formulierungen auf Verschreibungen auf.

In der Nähe von Reichenwalde kollidierten am Montagmorgen ein Auto und ein Motorrad. Die genauen Hintergründe zum Unfall sind unklar.

Am letzten Tag des Ultraschall Festivals lud das Magazin field notes Komponisten zum Talk über das Politische in der Musik. Ein ungeladener Gast hieß Überforderung.

Aus den DRK-Kliniken in Mitte und Westend soll eine gemeinsame, größere Klinik werden. Das ist offenbar eine Konsequenz aus der Krankenhausreform.

Der Goldene Bär ist die wichtigste Auszeichnung der Berlinale. Daneben werden mehrere Silberne Bären verliehen. Doch dafür muss eine Gießerei sie erst mal herstellen.

Tjarven Dyrssen (16) lässt sich im ersten Jahr zum Augenoptiker ausbilden und berichtet von seinen ersten Eindrücken. Folge 106 unserer Serie „Meine Lehre“

Anwohner alarmieren die Polizei, weil ein Mann laut in seiner Wohnung herumschreit. Als Polizisten ihn wegen seines Verhaltens einem Facharzt vorstellen wollen, verletzt er einen Beamten.

Kurz vor dem Amtsantritt des designierten US-Präsidenten Donald Trump zeigen sich Dax-Anleger optimistisch. Der deutsche Leitindex stieg am Montag in der Spitze um 0,5 Prozent.

Eine verkorkste Vierschanzentournee und auch in Polen chancenlos. Die deutschen Skispringer stecken im Tief. Viele Mutmacher gibt es vor den Heim-Weltcups nicht.

Eastside Berlin muss um den Einzug in das Halbfinale in der Champions League zittern. Der fünfmalige Gewinner konnte im Hinspiel in Cartagena lediglich ein Spiel für sich entscheiden.

Die nächste Bewährungsprobe für den Meister. Ein Sieg bei Atlético - und das Achtelfinale wäre für Bayer Leverkusen zum Greifen nahe.

Der RBB zieht einen Teil seiner Berichterstattung zurück, weil Zweifel an Vorwürfen gegen den Berliner Grünen-Politiker Stefan Gelbhaar aufkamen. Senderkontrolleure wollen sich das näher ansehen.

Die Nordkoreaner können zwar kein Russisch und haben kaum Erfahrung in der Kriegsführung. Sie sind aber bereit, ihr Leben an der Front zu opfern. Die Soldaten sind wohl motivierter als Putins Truppen.

Der Dax steigt auf einen neuen Rekordwert. Das hat auch mit dem bevorstehenden Amtsantritt von US-Präsident Donald Trump und dessen Plänen zu tun.

Es ist die wohl größte Schneeballschlacht der Alpen: Im Salzburger Land steigen im März die Yukigassen-Meisterschaften. Eine spaßige Abwechslung abseits der Pisten und Loipen – jeder kann mitmachen.

Mehr als eine Million Ukrainer sind seit der russischen Invasion nach Deutschland geflüchtet. Die Regierung in ihrer Heimat räumt ihrer Rückkehr nun eine hohe Priorität ein.

Orban in Ungarn, Fico in der Slowakei – und vielleicht bald Herbert Kickl in Österreich: Orbans russlandnahe Allianz in Europa wird immer stärker. Wie konnte es so weit kommen?

Borussia Dortmund tritt in der Champions League in Bologna an. Die Partie ist weit über die Champions League hinaus bedeutsam. Die Erwartung hat der Geschäftsführer deutlich formuliert.

Bei dem Messerangriff im nordwestenglischen Southport werden drei Mädchen während eines Taylor-Swift-Tanzkurses getötet. Am ersten Prozesstag äußert sich der Angeklagte. Er sagt nur ein Wort.

124 Abgeordnete mehrerer Fraktionen wollen, dass das Parlament ein Verfahren zum Verbot der AfD beantragt. Das Bundesverfassungsgericht müsste diesen dann prüfen.

Oberbürgermeister Mike Schubert (SPD) hat Hilfe von 4,6 Millionen Euro allein für 2025 angekündigt. Der Sparhaushalt fällt etwas milder aus als gedacht.

Die Maul- und Klauenseuche drückt auf die Stimmung in der Agrarbranche – auch bei der Grünen Woche. Was bringen weitere Tests? Die Lage ist nach wie vor angespannt.

Mit seinem Vorstoß, künftig auch Pendler günstig in der City parken zu lassen, trifft CDU-Fraktionschef Dirk Stettner auf Widerspruch beim Koalitionspartner SPD.

Nach einer sexuellen Belästigung am Schlaatz ermittelt die Polizei. Der Täter konnte noch nicht gestellt werden. Bei dem Vorfall wurde eine 53-Jährige verletzt.

Der Verteidigungsminister forderte jüngst mehrfach eine Erhöhung des deutschen Wehrhaushaltes. Dabei hatte er im vergangenen Jahr einem Bericht zufolge viel weniger Geld ausgegeben als möglich.

Brandenburgs neue Innenministerin dringt auf eine verstärkte Rückführung von Ausländern ohne Bleiberecht. Sie kann sich auch mehr Kompetenzen für die Polizei bei bestimmten Einsätzen vorstellen.

Nächste Bewährungsprobe für den Meister. Ein Sieg bei Atlético - und das Achtelfinale wäre für Bayer Leverkusen zum Greifen nahe.

Wald und Forstwirtschaft sollen stärkere Bedeutung erhalten. Die Jagdbehörde wird aus der Forstbehörde herausgelöst und Chefsache des neuen Staatssekretärs Gregor Beyer.

Vor zwei Jahren soll eine Gruppe von jungen Menschen Rechtsradikale in Budapest angegriffen haben. Nun haben sich sieben Verdächtige gestellt – trotz drohender Auslieferung nach Ungarn.

EEG-Headsets erobern den Massenmarkt. Sie versprechen mentale Höchstleistungen und tiefere Entspannung – ganz ohne invasive Eingriffe. Doch was können die Geräte wirklich?

In der kalten Jahreszeit entwickeln Seebäder ihren ganz eigenen, stillen Charme. An den Stränden ist viel Platz. Das ist auch in Grömitz, Kellenhusen und Dahme so.

Der Jugendliche wurde am Sonntagabend unter einem Vorwand aus seiner Wohnung gelockt. Anschließend kam es zu einem Streit, bei dem er schwer verwundet wurde. Die Polizei nahm sieben Tatverdächtige fest.

Berlin-Reinickendorf soll eine neue Förderschule erhalten, das Grundstück steht fest. Jetzt soll alles ganz schnell gehen - zu schnell, findet der Reiterverein vor Ort. Ein Besuch in Tegel.

Polizisten kontrollieren am Sonntag einen auffälligen Autofahrer. Dieser will nicht mit auf eine Dienststelle und flieht. In einem Gleisbett der Ringbahn wird der Mann festgenommen.
Am Tag der Amtseinführung von Donald Trump als US-Präsident präsentiert ein internationales Team Daten zum Vertrauen in Forscher. Weltweit sieht es ganz gut aus, es gibt aber Kritik an der Studie.

Bei der Ausschreibung für die Heim-EM 2024 hatte die Telekom sich überraschend gegen die beiden öffentlich-rechtlichen Sender durchgesetzt. Durch Sub-Lizenzen konnten sie nur einen Teil der Spiele zeigen.

Er spricht von Zollkrieg und spekuliert darüber, Kanada zu annektieren. Wie ernst sind Trumps Drohungen? Und was bedeuten sie für den nördlichen Nachbarn der USA? Drei Fachleute antworten.

In der französischen Kapitale greift die Bürgermeisterin durch und steigert trickreich die Attraktivität des öffentlichen Nahverkehrs. Unser Kolumnist Nikolaus Bernau träumt davon für seine Stadt.

Nach etwas mehr als einem Jahr in der Bundesliga zieht es den Dänen Jacob Friis nach Finnland. Dort wartet eine besondere Aufgabe auf den 48-Jährigen.

Ein Kurzfilm der Brandenburger AfD enthält umstrittene Darstellungen. Die Kommission für Jugendmedienschutz fordert Konsequenzen. Die Partei will juristisch dagegen vorgehen.

Viele Menschen in Deutschland fürchten Altersarmut – selbst Gutverdiener. Zu Recht? Finanzpsychologin Julia Pitters verrät, wieso Ängste nicht weiterhelfen – und wie es gelingt, gelassen zu bleiben.
öffnet in neuem Tab oder Fenster